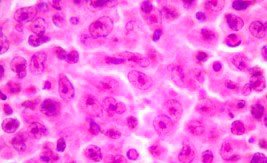
linfoma_b_267_163.jpg
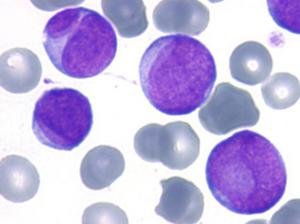
Leucemia_promielocitica_aguda.jpg

Debates no manejo de tumores neuroendócrinos
 Os tumores neuroendócrinos (TNEs) são tema do artigo da oncologista Renata D’Alpino Peixoto (foto) e do cirurgião Marcos Belotto, do Centro Oncológico Antônio Ermírio de Moraes. Os tumores neuroendócrinos (TNEs) compreendem uma grande família de neoplasias epiteliais heterogêneas com diferenciação predominantemente neuroendócrina, e seu tratamento ainda é motivo de controvérsia.
Os tumores neuroendócrinos (TNEs) são tema do artigo da oncologista Renata D’Alpino Peixoto (foto) e do cirurgião Marcos Belotto, do Centro Oncológico Antônio Ermírio de Moraes. Os tumores neuroendócrinos (TNEs) compreendem uma grande família de neoplasias epiteliais heterogêneas com diferenciação predominantemente neuroendócrina, e seu tratamento ainda é motivo de controvérsia.



 O oncologista clínico Luiz Henrique de Lima Araujo (foto), do Grupo COI, comenta dois artigos científicos publicados por importantes periódicos científicos que contaram com a sua participação. No Plos One, o especialista abordou a influência dos fatores pré-analíticos na qualidade final do sequenciamento. Outro artigo, publicado no Journal of the National Cancer Institute (JNCI), trouxe os resultados de uma pesquisa que buscou compreender os mecanismos biológicos por trás do controle imune do câncer.
O oncologista clínico Luiz Henrique de Lima Araujo (foto), do Grupo COI, comenta dois artigos científicos publicados por importantes periódicos científicos que contaram com a sua participação. No Plos One, o especialista abordou a influência dos fatores pré-analíticos na qualidade final do sequenciamento. Outro artigo, publicado no Journal of the National Cancer Institute (JNCI), trouxe os resultados de uma pesquisa que buscou compreender os mecanismos biológicos por trás do controle imune do câncer. Em artigo exclusivo, os oncologistas Raphael Brandão Moreira (foto), ex residente chefe do Centro Oncológico Antônio Ermírio de Moraes, e Fabio Augusto Schutz, coordenador da oncologia clínica do Hospital São Joaquim - Beneficência Portuguesa de São Paulo, analisam o cenário da imunoterapia no câncer de bexiga, uma alternativa promissora no tratamento da doença.
Em artigo exclusivo, os oncologistas Raphael Brandão Moreira (foto), ex residente chefe do Centro Oncológico Antônio Ermírio de Moraes, e Fabio Augusto Schutz, coordenador da oncologia clínica do Hospital São Joaquim - Beneficência Portuguesa de São Paulo, analisam o cenário da imunoterapia no câncer de bexiga, uma alternativa promissora no tratamento da doença. Onconews acompanha a agenda científica do congresso Hemo 2015 e traz artigos de importantes nomes da onco-hematologia brasileira. Angelo Maiolino (foto), chefe do Serviço de Hematologia e Transplante de Medula Óssea da Faculdade de Medicina da UFRJ, aborda o transplante autólogo de células-tronco hematopoéticas e os avanços no tratamento do mieloma múltiplo.
Onconews acompanha a agenda científica do congresso Hemo 2015 e traz artigos de importantes nomes da onco-hematologia brasileira. Angelo Maiolino (foto), chefe do Serviço de Hematologia e Transplante de Medula Óssea da Faculdade de Medicina da UFRJ, aborda o transplante autólogo de células-tronco hematopoéticas e os avanços no tratamento do mieloma múltiplo. O tratamento da recaída é tema do artigo de Lívia Caroline Barbosa Mariano, médica hematologista do Centro Paulista de Oncologia (CPO) e do Centro de Transplante de Medula Óssea do Hospital das Clínicas da Faculdade de Medicina da Universidade de São Paulo (USP), e Jacques Tabacof, oncologista-hematologista do Centro Paulista de Oncologia e Coordenador de Oncologia do Hospital Alemão Oswaldo Cruz.
O tratamento da recaída é tema do artigo de Lívia Caroline Barbosa Mariano, médica hematologista do Centro Paulista de Oncologia (CPO) e do Centro de Transplante de Medula Óssea do Hospital das Clínicas da Faculdade de Medicina da Universidade de São Paulo (USP), e Jacques Tabacof, oncologista-hematologista do Centro Paulista de Oncologia e Coordenador de Oncologia do Hospital Alemão Oswaldo Cruz. A leucemia promielocítica aguda (LPA), um subtipo único de leucemia mielóide aguda (LMA), acomete indivíduos de qualquer faixa etária, com predomínio nos adultos jovens, sem diferença de incidência entre os sexos. A LPA, doença com características clínicas, morfológicas e biológicas peculiares, é tema do artigo de Luísa Correa de Araújo Koury, médica hematologista e aluna de doutorado do Programa de Oncologia Clínica, Células Tronco e Terapia Celular da Faculdade de Medicina de Ribeirão Preto da Universidade de São Paulo (USP); e Eduardo M. Rego, professor titular e coordenador do International Consortium on Acute Leukemias (ICAL); Divisão de Hematologia e Oncologia Clínica, Departamento de Clínica Médica, Faculdade de Medicina de Ribeirão Preto da USP.
A leucemia promielocítica aguda (LPA), um subtipo único de leucemia mielóide aguda (LMA), acomete indivíduos de qualquer faixa etária, com predomínio nos adultos jovens, sem diferença de incidência entre os sexos. A LPA, doença com características clínicas, morfológicas e biológicas peculiares, é tema do artigo de Luísa Correa de Araújo Koury, médica hematologista e aluna de doutorado do Programa de Oncologia Clínica, Células Tronco e Terapia Celular da Faculdade de Medicina de Ribeirão Preto da Universidade de São Paulo (USP); e Eduardo M. Rego, professor titular e coordenador do International Consortium on Acute Leukemias (ICAL); Divisão de Hematologia e Oncologia Clínica, Departamento de Clínica Médica, Faculdade de Medicina de Ribeirão Preto da USP. Eduardo Cerello Chapchap, médico assistente do Centro de Oncologia e Hematologia do Hospital Israelita Albert Einstein (HIAE), e José Mauro Kutner, hematologista e gerente médico do Departamento de Hemoterapia e Terapia Celular do HIAE analisam em artigo o tratamento de primeira linha no mieloma múltiplo,segunda neoplasia hematológica mais frequente (10% das neoplasias), sendo menos frequente apenas que o Linfoma não–Hodgkin.
Eduardo Cerello Chapchap, médico assistente do Centro de Oncologia e Hematologia do Hospital Israelita Albert Einstein (HIAE), e José Mauro Kutner, hematologista e gerente médico do Departamento de Hemoterapia e Terapia Celular do HIAE analisam em artigo o tratamento de primeira linha no mieloma múltiplo,segunda neoplasia hematológica mais frequente (10% das neoplasias), sendo menos frequente apenas que o Linfoma não–Hodgkin. Nos últimos anos, grandes avanços ocorreram na compreensão da biologia e no tratamento do mieloma múltiplo. A introdução das chamadas novas drogas, as imunomoduladoras (talidomida, lenalidomida), inibidores de proteassoma (bortezomibe, carfilzomibe) e mais recentemente a imunoterapia, tem levado ao aumento da sobrevida. Gracia A Martinez, médica assistente do Hospital das Clínicas da Faculdade de Medicina da Universidade de São Paulo (HC-FMUSP) e do Instituto do Câncer do Estado de São Paulo (ICESP), fala sobre como refinamento na pesquisa de fatores de prognóstico pode melhorar a estratificação dos pacientes em subgrupos mais homogêneos quanto à expectativa de sobrevida.
Nos últimos anos, grandes avanços ocorreram na compreensão da biologia e no tratamento do mieloma múltiplo. A introdução das chamadas novas drogas, as imunomoduladoras (talidomida, lenalidomida), inibidores de proteassoma (bortezomibe, carfilzomibe) e mais recentemente a imunoterapia, tem levado ao aumento da sobrevida. Gracia A Martinez, médica assistente do Hospital das Clínicas da Faculdade de Medicina da Universidade de São Paulo (HC-FMUSP) e do Instituto do Câncer do Estado de São Paulo (ICESP), fala sobre como refinamento na pesquisa de fatores de prognóstico pode melhorar a estratificação dos pacientes em subgrupos mais homogêneos quanto à expectativa de sobrevida. Em artigo exclusivo, o oncologista clínico Diocésio Alves Pinto de Andrade, membro do Grupo Brasileiro de Tumores Ginecológicos (EVA), comenta estudo publicado no Journal of Clinical Oncology que avaliou a indicação de hormonioterapia adjuvante no câncer de ovário ressecado. Apesar do baixo número de pacientes incluídos, o resultado do estudo é de certa forma surpreendente ao demonstrar uma diminuição do risco de óbito de 37% em favor das pacientes que receberam hormonioterapia adjuvante.
Em artigo exclusivo, o oncologista clínico Diocésio Alves Pinto de Andrade, membro do Grupo Brasileiro de Tumores Ginecológicos (EVA), comenta estudo publicado no Journal of Clinical Oncology que avaliou a indicação de hormonioterapia adjuvante no câncer de ovário ressecado. Apesar do baixo número de pacientes incluídos, o resultado do estudo é de certa forma surpreendente ao demonstrar uma diminuição do risco de óbito de 37% em favor das pacientes que receberam hormonioterapia adjuvante.
